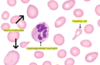

Vitamin deficiencies Flashcards
(58 cards)
What is the primary disease caused by vitamin A deficiency?
Xerophthalmia
Describes a spectrum of ocular manifestations that occur secondarily to systemic vitamin A (retinol) deficiency
Describe the aetiology of xerophthalmia
Vitamin A (retinol) is required for formation of rhodopsin, photoreceptor pigment in the retina.
Keratinisation of the eyes → dryness of the conjunctiva and cornea
- Conjunctivae develop oval/triangular spots (Bitots spots)
- Cornea becomes cloudy and soft.
State some causes of vitmain A deficiency
- Conditions that affect pancreatic function, such as:
- cystic fibrosis
- chronic pancreatitis
- Conditions that lead to reduced absorption of vitamin A, such as:
- previous gastric surgery
- Crohn’s disease
-
Liver conditions:
- Liver stores vitamin A
-
Inadequate intake:
- Common in southern and eastern Asia where rice is the staple food
- rice is devoid of beta carotene (precursor to vit A)
What are the presenting symptoms of vitamin A deficiency?
- First symptom = night blindness
- multiple erosions develop = eventual blindness
- Drying, scaling and follicular thickening of the skin due to keratinisation
- Respiratory infections due to keratinisation of mucous membranes in respiratory tract.

Recognise the signs of vitamin A deficiency
Visual ability
-
decreased visual acuity in dim light
- measure using Snellen chart
- visual field loss
On Fundoscopy:
-
Retinal vascular attenuation
- narrowing of the retinal arterioles.
- Bitots spots on conjunctiva
- peripheral chorioretinal degeneration
On observation
- corneal xerosis – cornea appears dry and dull
- corneal ulcerations
- Conjunctival xerosis – dry, dull and thick
What is the final stage of xerophthalmia before blindness?
Keratomalacia
softening of cornea, followed by perforation of eyeball and blindness
State appropriate investigations for Vit A deficiency
Check sight in darkness
Bloods:
- Serum vitamin A level
- Serum retinol binding protein
- Zinc levels – zinc deficiency can interfere with production of retinol-binding protein
- Iron studies – can affect metabolism of vitamin A
- FBC: for anaemia or infection
Identify the possible complications of vitamin A deficiency
- Blindness
- Respiratory infections
- Prognosis good if treated early, before blindness progresses
Vitamin B1 (thiamine)deficiency precipitates which disease?
Beri Beri
Can progress to Wernicke’s encephalopathy
Explain the risk factors for vitamin B1 deficiency
Developed world:
- Chronic alcohol abuse- commonest
-
Refeeding and TPN
- B1 = co-factor in the metabolism of carbohydrates
- GI surgery, including bariatric surgery, can lead to a reduced area of intestinal and gastric mucosa for absorbing thiamine
-
Cancer and chemotherapy
- N+V, anorexia, malabsorption
Developing world:
-
High levels of milled (polished) rice
- polished rice is deficient in thiamine.
- wholegrains are rich however
-
High consumption of tea, coffee, fermented fish and betel nuts
- Contain thiaminases- break down thiamine in food
-
Malnutrition
- magnesium deifciency (cofactor)
- B1 deficiency
- Prolonged vomiting/ AWD
How does alcohol abuse cause thiamine deficiency?
Alcohol blocks the active-transport mechanism for the absorption of thiamine in the GI tract
What are the 2 types fo Beri-beri? Give examples of syndromes.
Dry beri beri
- nervous system involvment- peripheral neuropathy
- poor caloric intake and physical inactivity
- Wernicke’s encephalopathy and Korsakoff syndrome
Wet beri beri
- cardiovascular involvement
- Leads to high-output cardiac failure with peripheral vasodilation, peripheral oedema, and orthopnoea
Summarise the epidemiology of vitamin B deficiency
Developed world-
- prevalence of Wernicke’s encephalopathy = 0.1-1%
- due to chronic alcohol abuse, in the context of poor nutritional intake
Developing-
- prevalence of B1 deficiency = 58-66% in East Asian countries
- Due to the large-scale consumption of thiamine-depleted polished rice.
What are the presenting symtoms of wet beriberi?
Symptom of cardiac failure in wet beriberi due to acute or chronic deficiency:
- dyspnoea
- orthopnoea
- tachycardia, palpitations
- peripheral cyanosis
- peripheral oedema
What are the presenting signs/symptoms of dry beriberi?
- Decreased sensation - distal peripheral polyneuropathy (particularly of the legs)
- Parasthesia
- Reduced knee jerks and other tendon reflexes
- Progressive severe muscle weakness with muscle wasting
What is the triad of mental states in Wernicke’s encephalopathy?
- Acute confusion
- Ataxia
- Ocular abnormalities (e.g., nystagmus and strabismus).
NOTE: common, non-specific sign in patients presenting to hospital.
State some early signs of B1 deficiency
Fatigue
Muscle aches
Generate a management plan for vitamin B deficiency
Thiamine replacement therapy-
- IV for acute, oral for alcohol withdrawal and F/U
- Pabrinex
- Magnesium, potassium, and phosphate adjunct
- If there is coexisting hypoglycaemia, ensure thiamine given before glucose
Identify appropriate investigations for vitamin B deficiency
Diagnosis mainly clinical
Bloods:
-
erythrocyte thiamine pyrophosphate
- indicates thimaine stores
- takes time- used retrospectively to confirm diagnosis (Tx immediately)
- ABG + lactate- B1 deficiency is associated with lactic acidosis
Summarise the prognosis for patients with vitamin B deficiency
Good if treated early, but Korsakoff is minimally reversible
What is the outcome of severe vitamin C deficiency?
Scurvy
Most key clinical manifestations are related to impaired collagen synthesis.
What are the consequences of vitamin C deficiency?
wound healing
immune function
iron absorption
What are the commonest forms of Vit C deficiency?
- famine and refugee populations
- feeding infants on cow’s milk
- psychiatric disorders, alcohol abuse
- haemodialysis- dialyses vitamin C
- 3Ss- sepsis, smoking, surgery
- critical illness and acute hospitalisation
- pancreatitis